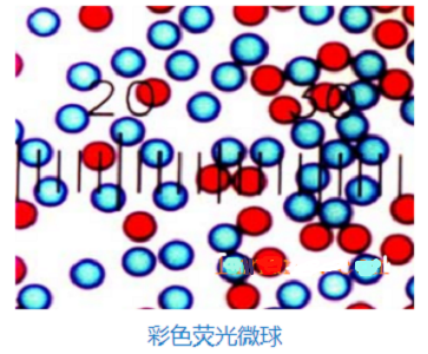
彩色乳膠微球 彩色乳膠微球

彩色乳膠微球
產(chǎn)品名稱:彩色乳膠微球
產(chǎn)品描述:
彩色乳膠微球
彩色微球,染料填充微球內(nèi)部,不易發(fā)生色彩漂白,批次穩(wěn)定性好,有多種規(guī)格可供選擇,我們也接受定制服務(wù)。彩色微球中常用于側(cè)向?qū)游鰧嶒灪湍z乳凝集試驗。我們的彩色聚苯乙烯微球填充了,對比度高的油溶性染料,我們的調(diào)色板顏色代表我們色彩鮮亮的標(biāo)準(zhǔn)。非官能團化和羧基化的微球支持物理吸附和共價結(jié)合的不同方法,規(guī)格顏色及官能團可定制。
彩色微球主要特點
? 粒徑尺寸的選擇在0.1μm至0.5μm
? 可接受不同大小,不同顏色以及不同表面修飾的定制
? 填充了近20%的油溶性彩色染料,對比度高,顏色深
? 粒徑高度均一(CV%小于5%),批間差小,重復(fù)性好
彩色微球技術(shù)參數(shù)
? 成分: 含有彩色染料的聚苯乙烯 (Dyed Polystyrene)
? 密度: 1.05 g/cm3
? 折射指數(shù): 1.59 @ 589 nm (25°C)
? 添加劑: 含有微量的表面活性劑

以上資料來自小編axc,2022.11.23
以上文中提到的產(chǎn)品僅用于科研,不能用于人體。
聯(lián)系我們:
郵箱:2519696869@qq.com
QQ: 2519696869
電話:18066853083
微信:18066853083
公司介紹:
西安齊岳生物科技有限公司是集化學(xué)科研和定制與一體的高科技化學(xué)公司。業(yè)務(wù)范圍包括化學(xué)試劑和產(chǎn)品的研發(fā)、生產(chǎn)、銷售等。涉及產(chǎn)品為通用試劑的分銷、非通用試劑的定制與研發(fā),涵蓋生物科技、化學(xué)品、中間體和化工材料等領(lǐng)域。
主營產(chǎn)品:COF、MOF單體系列:三蝶烯衍生物、金剛烷衍生物、四苯甲烷衍生物、peg、上轉(zhuǎn)換、石墨烯、光電材料、點擊化學(xué)、凝集素、載玻片、蛋白質(zhì)交聯(lián)劑、脂質(zhì)體、蛋白、多肽、氨基酸、糖化學(xué)等。


